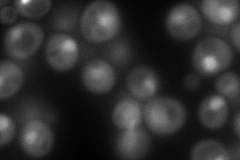
YGR275W
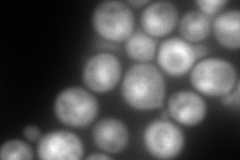
YGR275W
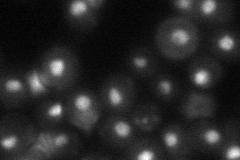
YGR275W

View description
Component of both the SWI/SNF and RSC chromatin remodeling complexes, suggested role in chromosome maintenance; possible weak regulator of Ty1 transposition
Localization:
Intensity:
Fold change:
Significance:
-
C’ GFP library in SD

nucleus29.38 -
N' NOP1pr-GFP in SD
nucleus149.369 -
N' TEF2pr-mCherry in SD
nucleus362.556 -
N' NATIVEpr-GFP in SD
nucleus44.2347 -
N' TEF2pr-VC and Cyto-VN in SD

nucleus63.3392 -
C’ GFP library in SD+DTT

nucleus35.381.2No -
C’ GFP library in SD+H2O2

nucleus31.651.07No -
C’ GFP library in Starvation Media

nucleus47.711.62Yes -
C’ GFP library on the background of Pup2-DaMP

nucleus -
C’ GFP library on the background of CCT mutant

nucleus30.21461.02822No
